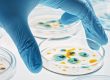

Protecting Residents from Respiratory Illness: 2024 Vaccination Recommendations
Long-term care and assisted living communities are home to many older adults who are at increased risk of severe illness from influenza, COVID-19, RSV and pneumococcal disease. Outbreaks in these communities can have devastating consequences. By getting vaccinated, residents can protect themselves and help prevent the spread to other residents, family, and community staff.
Influenza (Flu) Vaccination
People 65 years and older are at highest risk of developing complications from flu. Getting a flu vaccine is the best way to protect against getting the flu. For older adults, getting a flu vaccine reduces hospitalizations by 40% – 60%.
An annual flu vaccine is recommended for everyone aged 6 months and older. The best time to receive a flu vaccine is September through October. Trivalent flu vaccines are available this year and offer similar protection as quadrivalent vaccines.
Receiving a flu vaccine reduces the risk for:
- Illness/symptoms from flu
- Hospitalization
- Admission to the ICU
- Dying from flu or its complications
COVID-19 Vaccination
Older adults are at the highest risk of getting COVID-19 and experiencing illness. More than 81% of COVID-19 deaths occur in people over age 65. Underlying health conditions increase the risk of severe illness from COVID-19.
The Centers for Disease Control and Prevention (CDC) recommends individuals receive an updated 2024-2025 COVID-19 vaccine, even if they have received previously recommended COVID-19 vaccines. Receiving an updated 2024-2025 COVID-19 vaccine can restore and enhance protection against currently circulating virus variants.
Benefits of receiving an updated COVID-19 vaccine include:
- Reduced risk of getting seriously ill and of long COVID-19
- A safer way to build protection than getting infected
- Added protection for those who have been previously infected, including protection against being hospitalized
- Reduced risk of death from COVID-19 or related complications
Respiratory Syncytial Virus (RSV)
RSV is a common virus that infects the respiratory tract and lungs. It causes cold-like symptoms but can lead to severe illness like pneumonia, with up to 160,000 hospitalizations and 10,000 deaths annually in older adults. Severe cases may include fever, severe cough, wheezing, difficult or rapid breathing, and discoloration of the skin.
The RSV vaccine is over 80% effective in preventing lower respiratory tract disease like pneumonia. RSV vaccination also reduces the risk for RSV-related hospitalization and reduces the severity of RSV symptoms. Clinical trial data suggests protection can last for at least two years.
Why vaccinate against RSV now when it wasn’t recommended before? Scientists have worked on a safe, effective RSV vaccine since the 1980s. A 2013 breakthrough on how the virus worked led to FDA approval of the first vaccines in May 2023. Three vaccines are now available for older adults.
Who should get the RSV vaccine?
- All adults aged 75 years and older
- Adults aged 60-74 years who are at increased risk for severe infection
- Chronic medical conditions, especially lung or heart disease
- Reside in long-term care communities
The best time to vaccinate against RSV is before it spreads, typically late summer or early fall, but it can be given anytime as RSV cases occur year-round. Only a single dose of RSV vaccine is recommended currently.
Pneumococcal Vaccination
Pneumococcal disease is a bacterial infection that can range from mild to severe and is the is the most common bacterial cause of pneumonia that leads to hospitalization. Severe diseases include invasive lung, blood and brain infections including pneumonia, sepsis and meningitis.
Pneumococcal vaccine is approximately 60-75% effective against vaccine-type invasive pneumococcal disease and 45% effective against vaccine-type pneumococcal pneumonia.
All adults 65 years and older and adults aged 60-74 years who are at increased risk for severe infection should receive a pneumococcal vaccine. Benefits of receiving a pneumococcal vaccine include:
- Reduced risk for severe disease which may lead to hospitalization and death
- Reduced risk of spread of pneumococcal bacteria
Pneumococcal vaccines can be given at anytime, independent of season or time of year
Multiple pneumococcal vaccines are currently available including Capvaxive (PCV21), Prevnar 20 (PCV20), Vaxneuvance (PCV15) and Pneumovax (PPSV23). Your Guardian pharmacist or nurse is available to help choose which vaccine is best for each individual.
It’s important to note that flu, COVID-19, pneumococcal and RSV vaccines are not recommended for people who have had a severe allergic reaction to a previous dose of the vaccine or vaccine component.
On-Site Community Vaccination Clinics
Guardian pharmacies offer on-site vaccination clinics at your community to help protect residents from respiratory illness this season. There are many benefits to choosing Guardian Pharmacy vaccinators, including:
- Comfort and ease of personally knowing your vaccine team
- Knowledge specific for your residents and community
- Convenient sign up thru a digital vaccine consent
- Finalized clinic reports sent to your community and readily available for your access
Contact your local Guardian Pharmacy to inquire about on-site vaccination clinics or for more information about vaccinations to protect residents from respiratory illness.

![Alzheimer’s disease is a devastating condition that affects millions of people worldwide, particularly older adults. This year, Guardian Pharmacy is proud to announce the Alzheimer's Association as our charity of choice. We recognize the critical importance of addressing this pervasive disease and supporting those affected by it. With each of our 48+ locations nationwide, we have a unique opportunity to make a significant impact in the communities we serve. Here’s why we’ve chosen to stand with the Alzheimer’s Association and how you can join us in making a difference. The Prevalence and Impact of Alzheimer’s Disease Alzheimer’s disease is a common condition among older adults, and its prevalence increases with age. Despite a slight decline in the proportion of older adults with dementia from 13% in 2011 to 10% in 2019, demographic shifts, particularly the aging baby boomer generation, are expected to drive an overall increase in the number of individuals affected by this disease. Quick Facts By age 65, approximately 10% of individuals are affected, a figure that escalates to as high as 50% among those aged 85 and older The diagnosis rate for Alzheimer’s doubles every five years beyond age 65 More than 7 million people aged 65 and older had dementia in 2020, a number that could surpass 9 million by 2030 and nearly 12 million by 2040 if current trends continue. The prevalence of Alzheimer's disease, related dementia, or cognitive impairment is high among nursing home residents, exceeding 40%. This statistic underscores the urgent need for specialized care and support within long-term care facilities, a demand set to grow alongside the projected rise in dementia cases in the coming decades. Dementia, encompassing Alzheimer’s disease and related disorders, profoundly impacts memory, cognition, and social functioning, severely curtailing independence and necessitating extensive caregiving. Not only does dementia take an emotional toll on families, but caring for a person living with dementia is also more expensive and time-consuming than other conditions common at older ages. Why Guardian is Committed Guardian Pharmacy serves more than 162,000 residents of long-term care facilities across the U.S. As a provider of pharmacy services to a large number of residents who may be affected by Alzheimer's disease, we see firsthand the impact this condition has on individuals, their families, and their caregivers. By choosing the Alzheimer's Association as our charity of choice for 2024, we are committing to support an organization that works tirelessly to advance dementia care and support those affected by Alzheimer's disease. This cause not only enhances our presence in our communities but also shows solidarity with the many individuals we serve who are directly affected by this disease. The Collective Impact Joining the Alzheimer's Association community of fundraisers has a profound impact. In FY23, contributions to the Alzheimer’s Association from donors and partners totaled over $374 million, directly supporting those affected by Alzheimer's and advancing research. The Walk to End Alzheimer's alone raised $89.5 million, engaging over 300,000 participants. Strategic fundraising efforts across various platforms have shown significant results, demonstrating the power of collective action in the fight against Alzheimer's. Together, we can make a real difference. What We’re Doing Each Guardian Pharmacy location is encouraged to form a team and connect with their local Alzheimer's Association chapter. Whether it’s participating in a Walk or Ride to End Alzheimer's, hosting educational events, or volunteering, each pharmacy’s involvement in their local community can create a meaningful contribution. For example, the Birmingham, Alabama pharmacy team showed incredible community spirit by rallying its employees to support The Alzheimer’s Association’s The Longest Day on June 20th through a baked goods silent auction. This event not only raised funds but also increased awareness about Alzheimer's disease within their community. [Read more about the Birmingham team's efforts] Our Goal Our goal for 2024 is for each of our 48+ pharmacy locations and our corporate support services to commit to building a team and getting involved. We recognize that no action is too small to make a big difference in the fight to #ENDALZ. Join Us in the Fight to #ENDALZ We invite everyone to join us in our stand against Alzheimer’s in 2024. Getting involved is easy. Sign up for an Alzheimer's Event near you, find volunteer opportunities in your community, or start your fundraiser event. By coming together as a community, we can make a significant impact in the fight against Alzheimer's disease. Join Guardian Pharmacy in supporting the Alzheimer’s Association and help us work towards a future without this devastating condition. Together, we can #ENDALZ.](https://guardianpharmacy.com/wp-content/uploads/2024/07/Purple-Ribbon-1179x500-1-110x80.jpg)